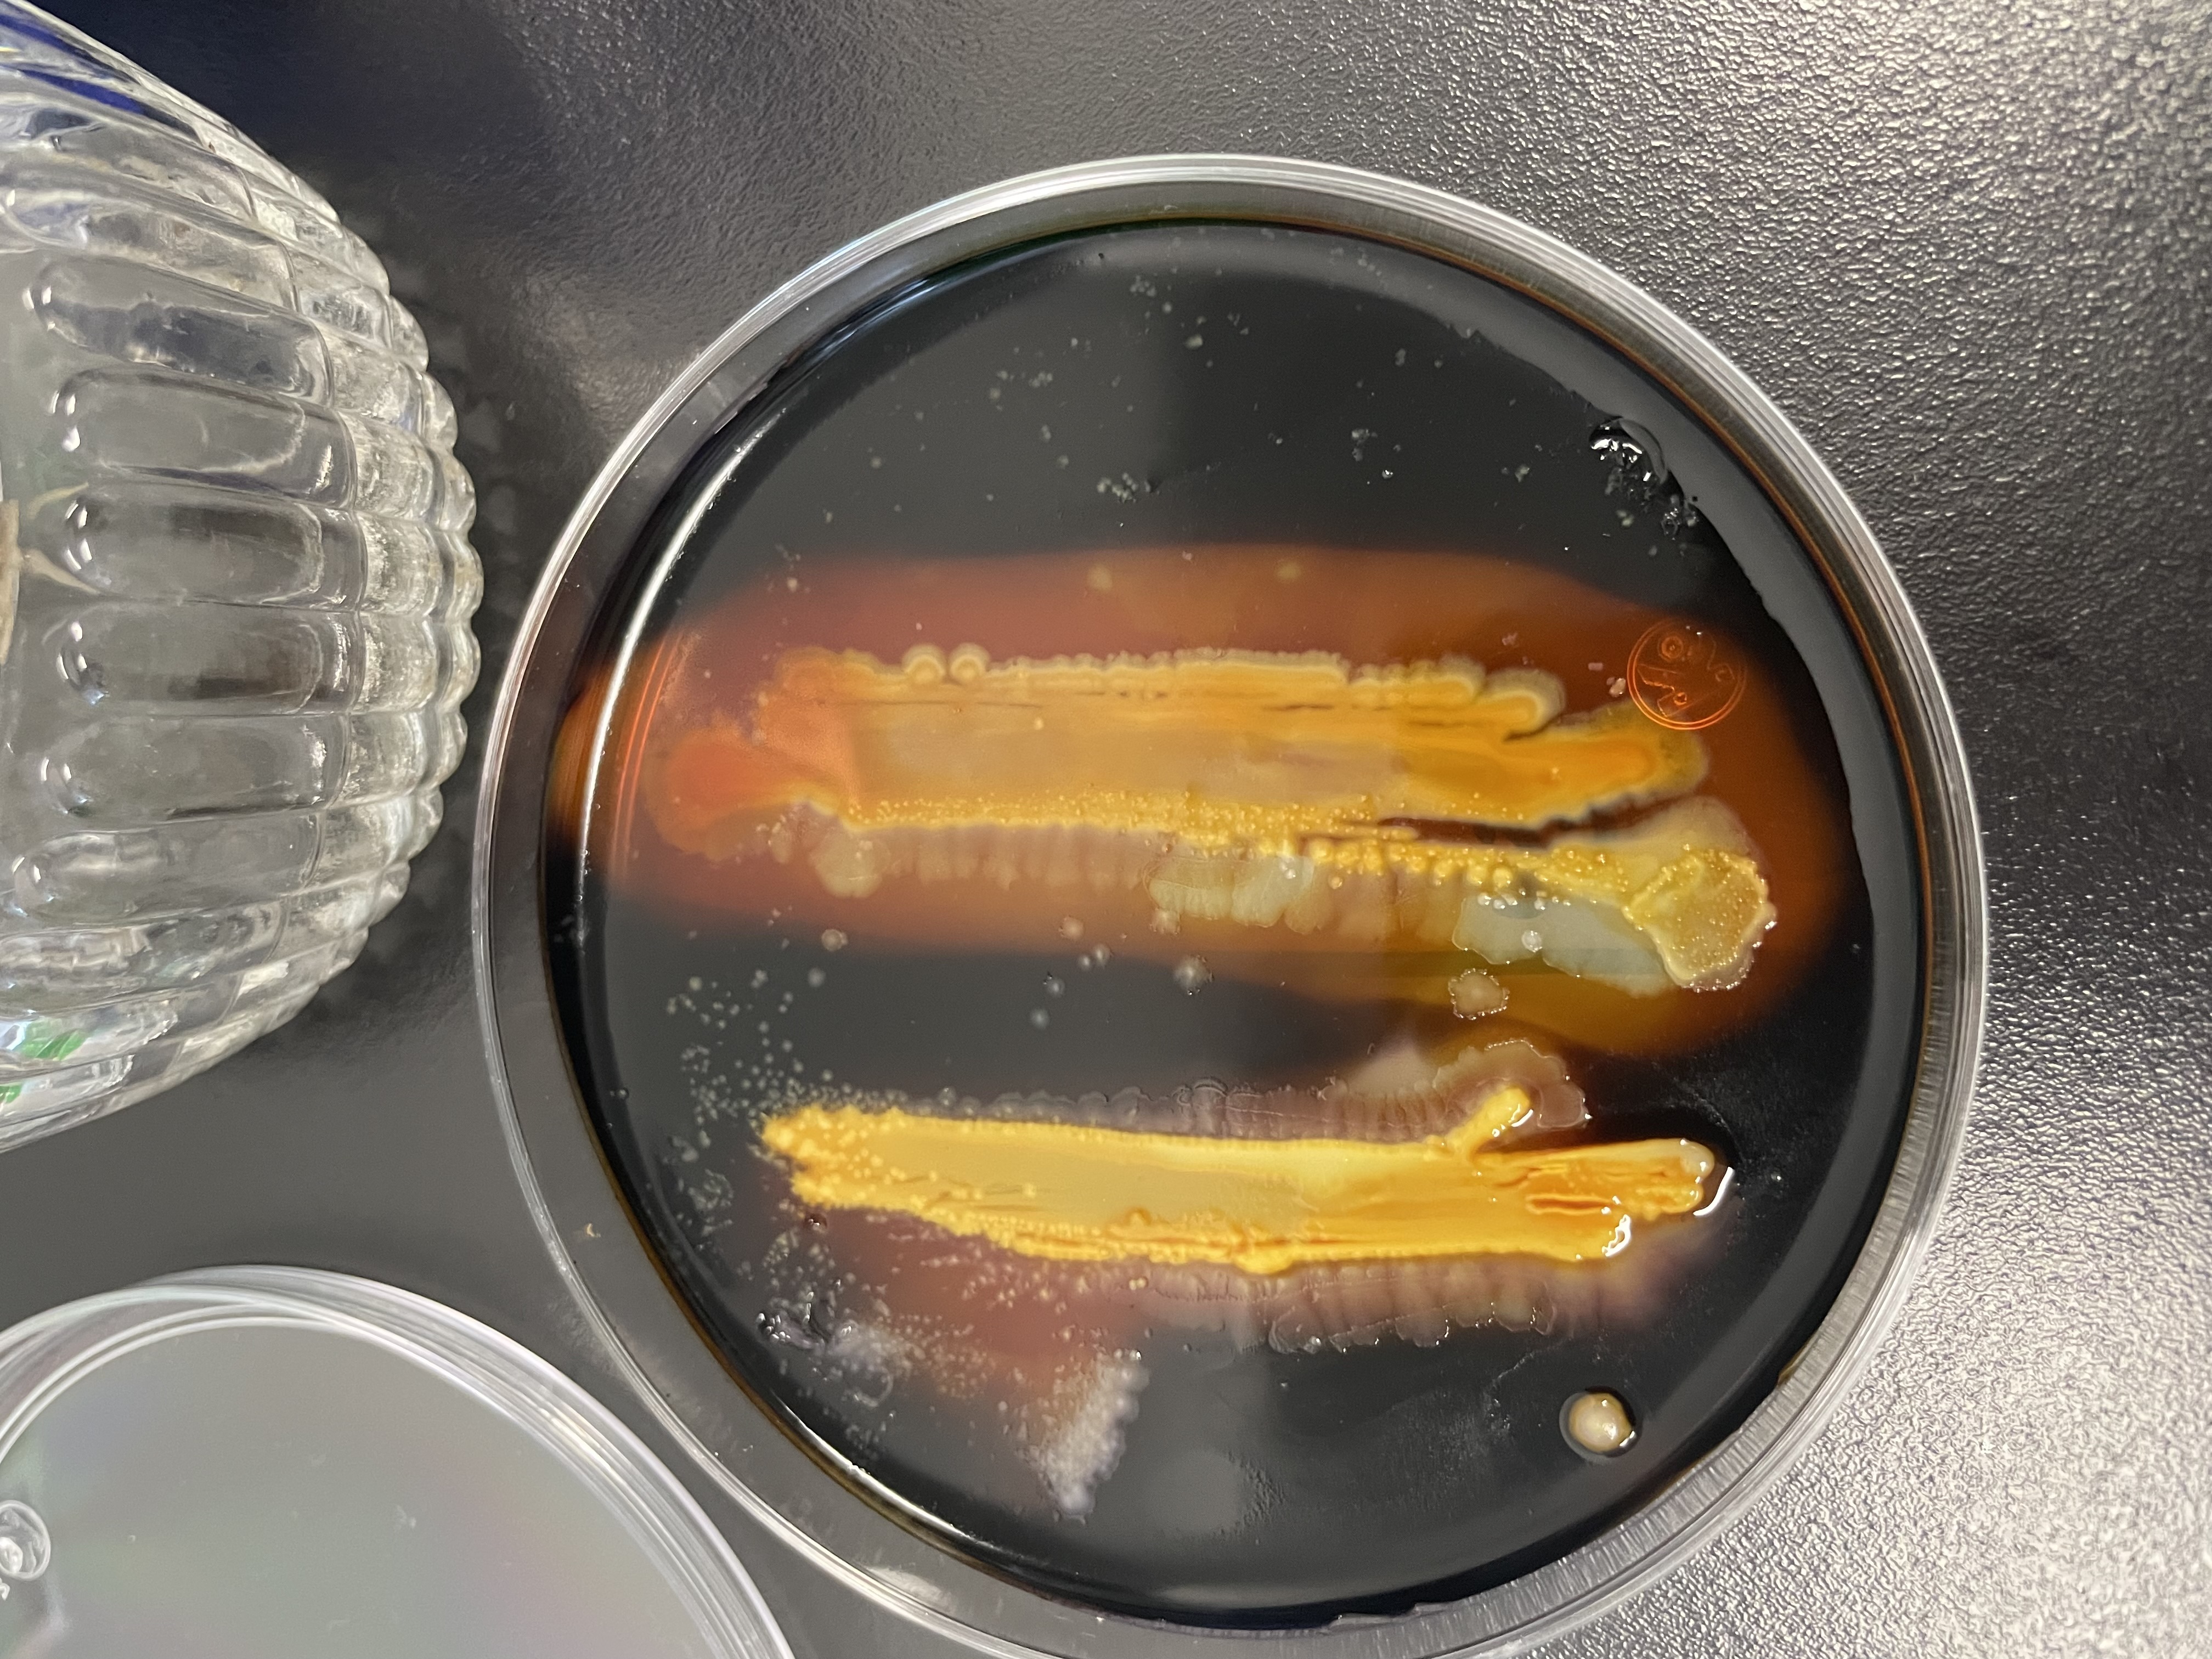

Vol. 54 Núm. 2 (2025)

Vol. 54 Núm. 2 (2025)
Publicado:
2025-07-01
Número completo
-
OBITUARIO Dr. Jörn Geister (1940 - 2025)
Visitas del artículo: 387- Visitas Ver Obituario Jörn Geister: 121
Articulos de investigación
-
Evaluación del potencial reproductivo de Gracilariopsis lemaneiformis (Gracilariales: Rhodophyta) en San Andrés, Pisco-Perú
Visitas del artículo: 861- Visitas PDF: 295
-
Estimación de tallas de anchoveta (Engraulis ringens) mediante ecosonda en áreas pesqueras de difícil acceso en la Región de Atacama, Chile
Visitas del artículo: 791- Visitas PDF: 304
-
Lista de especies y bibliografía de eunícidos (Eunicidae: Polychaeta: Annelida) del Caribe colombiano
Visitas del artículo: 882- Visitas PDF: 207
-
Investigación de la subsidencia antropogénica en Fremantle, Australia Occidental, mediante GPS, altimetría por satélite y datos de mareógrafos
Visitas del artículo: 794- Visitas PDF: 119
Articulos de revisión
-
Dos siglos de conocimiento sobre el género Dictyota (Phaeophyceae, Dictyotales): un enfoque histórico
Visitas del artículo: 914- Visitas PDF: 284
Notas científicas
-
Primer registro de la formación coralina de Bahía Honda, La Guajira, Colombia
Visitas del artículo: 818- Visitas PDF: 208
-
Descubrimiento de la vaca enmascarada Hypoplectrus providencianus (Serranidae) en la costa noroccidental de América del Sur
Visitas del artículo: 545- Visitas PDF: 155